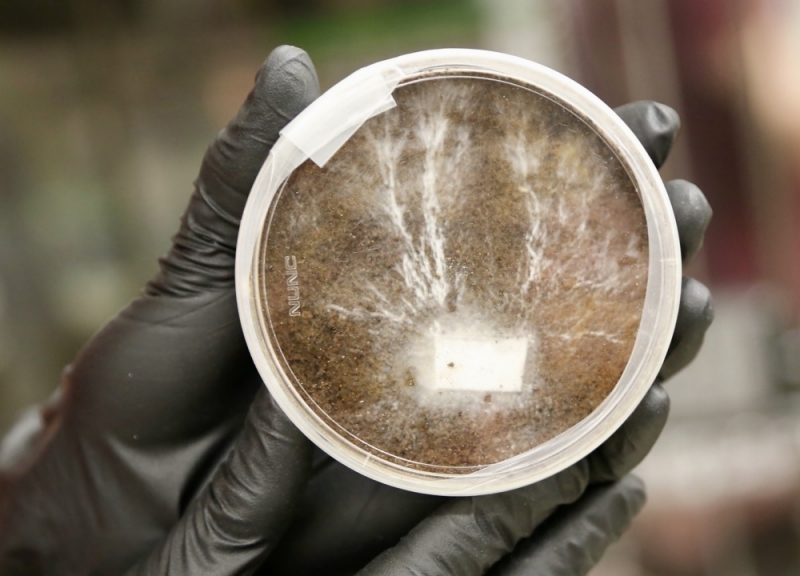

Lebensräume im Weltraum mit Pilzen
von Babett Hübler

Bauten und Möbel, die mit Hilfe von Pilzen entstehen, könnten auch auf der Erde Anwendung finden.
Bild: NASA, Rob Simmons
Die US-Raumfahrtbehörde NASA meldete im Januar 2020, dass sie im Forschungszentrum Ames des kalifornischen Silicon Valley Technologien erforscht, um mit Hilfe von Pilzen Strukturen für Bauten und Möbel wachsen zu lassen. Ziel des Myko-Architektur-Projekts seien Lebensräume für die Besiedelung des Mondes und des Mars durch den Menschen. Ebenso wären damit nachhaltigere Lebensweisen auf der Erde denkbar.
Lynn Rothschild, die Leiterin des Forschungsprojekts in der frühen Phase, vergleicht traditionelle Designs künstlicher Lebensräume für den Mars mit einer Schildkröte, die ihr Zuhause auf dem Rücken trägt. Das sei zwar zuverlässig, aber mit enormen Energiekosten verbunden. Deshalb wolle man Pilzgeflecht nutzen, um extraterrestrische Lebensräume zu schaffen.
Bauelemente mit lebenden Pilzfäden
Petrischale mit Myzel, das in simulierter Marserde wächst, auch bekannt als Mars-Regolith
Bild: NASA/Ames Research Center/Lynn Rothschild
Basis des visionären Konzepts ist ein kompaktes und leichtes Material aus den dünnen Zellfäden ruhender Pilze, das auf langen Reisen zu Orten wie dem Mars bestehen kann. Nach dem Rohbau soll das Myzel durch Wasserzugabe reaktiviert werden, damit die einzelnen Bauelemente zu einem Gerüst für einen voll funktionsfähigen menschlichen Lebensraum verwachsen. Gleichzeitig soll der Lebensraum sicher eingeschlossen sein, um eine Verunreinigung der Marsumgebung zu vermeiden.
Doch Pilze sind nur ein Teil des Lebensraumkonzepts. Wie die Astronauten sind Pilze Lebewesen, die essen und atmen müssen. Hier kommt ein Cyanobakterium ins Spiel, das mit Hilfe von Sonnenenergie Wasser und Kohlendioxid in Sauerstoff und Pilznahrung umwandelt. Dieses Ökosystem haben die Forscher in eine dreischichtige Kuppel implementiert.
Cyanobakterium liefert Nahrung und Sauerstoff

Ein Stuhl aus Myzelium nach 2-wöchigem Wachstum
Bild: 2018 Stanford-Brown-RISD iGEM Team
Die äußere Schicht besteht aus gefrorenem Wassereis, das idealerweise unmittelbar vor Ort erschlossen wird. Dieses Wasser dient als Strahlungsschutz und rieselt in die mittlere Schicht mit den Cyanobakterien. Jene Mikroorganismen nehmen das Wasser auf und betreiben mit Hilfe des von außen durch die Eisschicht einfallenden Lichts Fotosynthese, um Sauerstoff für die Astronauten und Nährstoffe für die innere Schicht aus dem Myzelium zu produzieren.
Diese innere Schicht wächst dann organisch zu einer robusten Behausung zusammen. Erst werden die Pilze reaktiviert, dann wachsen sie in einer geschlossenen Umgebung zusammen. Zuletzt wird das Ganze gebacken, um das Myzelium abzutöten. Das gewährleistet strukturelle Integrität und stellt sicher, dass kein Leben den Mars und bereits vorhandenes mikrobielles Leben kontaminiert. Darüber hinaus werden die Pilze gentechnisch so verändert, dass überlebende und frei werdende Pilzfäden außerhalb des Lebensraums nicht überleben können.
Ausblick in die Zukunft

Ziegelsteine, die im Rahmen des Myko-Architektur-Projekts aus Myzel, Hofabfällen und Holzspänen hergestellt werden
Bild: 2018 Stanford-Brown-RISD iGEM Team
Aber das soll erst der Anfang sein. Myzelium könnte für Wasserfiltrations- und Biomining-Systeme verwendet werden, um Mineralien aus dem Abwasser zu gewinnen – ein weiteres Projekt in Rothschilds Labor – sowie für biolumineszente Beleuchtung, Feuchtigkeitsregulierung und sogar für selbstheilende Lebensräume.
Die raue Umgebung des Mondes und des Mars wird jedenfalls neue Lebensweisen erfordern. Und da etwa 40 Prozent der Kohlenstoffemissionen auf unserem Planeten auf das Bauwesen zurückzuführen sind, besteht auch in unserem natürlichen Lebensraum zunehmend Bedarf an nachhaltigem und erschwinglichem Wohnraum. Ob in fernen Welten oder auf unserer eigenen, sich ständig verändernden Erde: Pilze könnten uns in die Zukunft bringen.

